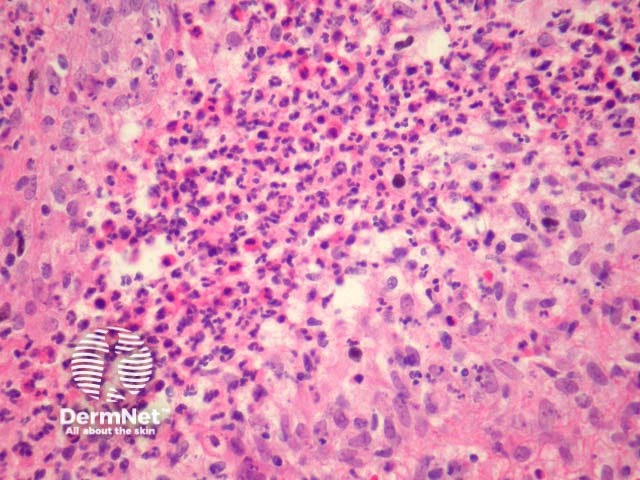
Figure 3
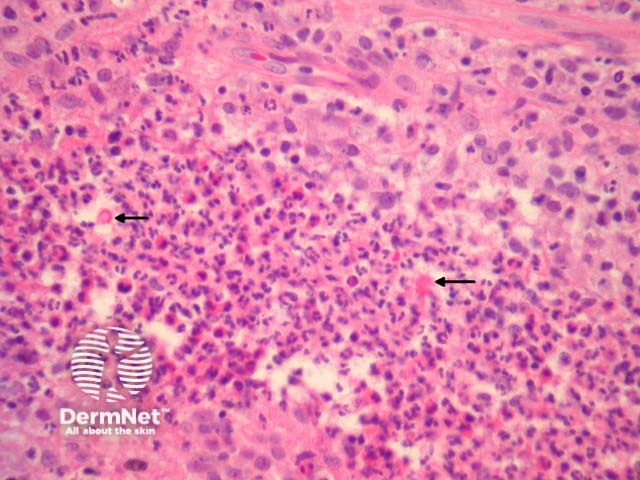
Figure 4

Main menu
Common skin conditions
NEWS
Join DermNet PRO
Read more
Quick links
Infections Diagnosis and testing
Authors: Assoc Prof Patrick Emanuel, Dermatopathologist, Auckland, New Zealand, 2013.
Infection of the dimorphic fungus, Sporothrix schenckii (sporotrichosis) usually occurs following percutaneous implantation of infected vegetable matter.
In sporotrichosis, sections show epidermal hyperplasia overlying a marked acute and chronic inflammatory response (figure 1). Higher power shows the inflammation infiltrates the overlying epidermis (figure 2). The infiltrate is polymorphous with giant cells, histiocytes, and focal neutrophilic microabscess formation (figure 3). Careful examination of multiple sections is required to identify the causative organisms (figure 4, arrows).
The organisms may be yeast-like, elongated or rarely hyphal. “Sporothrix asteroids” are densely eosinophilic yeast forms with a surrounding ray of eosinophilic material (figure 4, arrows)

Figure 1

Figure 2
Figure 3
Figure 4
The sporotrichosis organisms may be extremely difficult to find. PAS, GMS stains or immunohistochemical studies directed against the organisms can be used.
Blastomycosis – The reaction pattern is very similar. Special stains for fungal forms should be performed.
Atypical mycobacterial infection – These infections may also cause a massive epidermal response. Searching for the causative organisms and correlation with the cultures results can be helpful.
Keratoacanthoma – The surface epithelial hyperplasia may be difficult to distinguish from a keratoacanthoma.
Blastomycosis-like pyoderma – The inflammation is typically less striking and there is usually impressive solar elastosis.